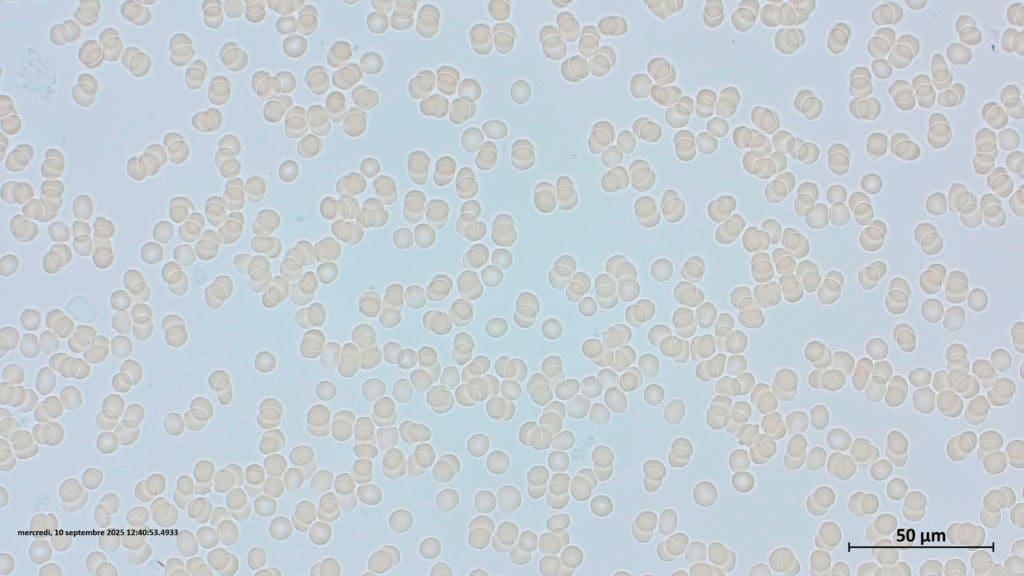

Bloedanalyse – Gebiodynamiseerd water bevordert een betere diffusie van zuurstof in het lichaam via het bloed!
Analyse, uitgevoerd met een Leitz Dialux 20EB microscoop, vergrotingen x 100, x 250, x 400, met helderveld en fasecontrast, op 25.07.2025 door Dr. JC Lebel, Zwitserland. Deze analyses werden bevestigd met een Zeiss microscoop met helderveld, vergroting x 200, x 400, door het IPR laboratorium (Institut de Pathologie Romand) van Dr. Seelentag, Lonay Zwitserland op 10.09.2025

Rode bloedcellen hopen zich op, het bloed circuleert minder soepel en er wordt minder zuurstof in het lichaam verspreid

Doordat de rode bloedcellen loskomen, neemt het bloed meer zuurstof op, circuleert het beter en verspreidt het meer zuurstof in het lichaam
Vergelijkende analyse van rode bloedcellen (Dr. J-C Lebel, analyse uitgevoerd in Viry op 25-07-2025):
- Vóór het drinken van gebiodynamiseerd water, zijn +/- 90% van de rode bloedcellen opgestapeld in de vorm van rolletjes.
- Na het drinken van 1 glas gebiodynamiseerd water is er een ontbinding van de rode bloedcellen binnen enkele minuten (slechts +/- 10% van de rode bloedcellen behouden de vorm van rolletjes) die opnieuw vrij zijn !
Deze ontstapeling van rode bloedcellen zorgt voor:
- Een grotere zuurstofopname door rode bloedcellen (vindt plaats over het gehele membraanoppervlak van de rode bloedcel)
- Een betere zuurstofdiffusie in het metabolisme (het membraan van de rode bloedcel vervormt gemakkelijker, wat de vloeibaarheid van de bloedcirculatie in de haarvaten verbetert en haar contactoppervlak met de haarvatwanden vergroot, wat de gas- en stofwisselingsuitwisselingen versnelt).
Dit heeft als gevolg een:
- Verbeterde fysieke prestaties,
- Verlaagde zuurtegraad van het bloed,
- Betere ATP-productie door mitochondriën (de voornamelijke energiebron van de cel),
- Verbeterde efficiëntie van witte bloedcellen (immuunsysteem)

Samenvatting van de analyses tussen 25.07.2025 en 20.09.2025:

1/ Begin van het ontstapelen van de rollen:
- Tussen +/- 15 en 30 minuten na het drinken van 40 cl gebiodynamiseerd water
2/ Ontstapelingspercentage van de rode bloedcellenrollen:
- Van 80% tot 100% (-> de rode bloedcellen komen weer vrij!)
3/ Duur van het effect van gebiodynamiseerd water op de rode bloedcellen:
- 9 uur opeenvolgend, 50% na 9:00 uur -> 18:00 uur, 0% > 39 uur ; Deze observatie komt overeen met de conclusies van de biofotonische analyse
Analyse door het IPR Laboratorium (Instituut Pathologie Romand), Dr. W. Seelentag
De analyse van het laboratorium van Dr. Seelentag’s IPR (Institut de Pathologie Romand) in Lonay, Zwitserland, uitgevoerd op 10 september 2025, bevestigt de ontstapeling van rode bloedcelrollen die vrijkomen na hydratatie met gebiodynamiseerd water (90% -> 10% in 13 minuten!), wat absoluut niet het geval is na hydratatie met kraanwater!
=> Gebiodynamiseerd water zorgt, dankzij zijn bijkomende elektronegativiteit afkomstig van zijn extra energie (zie onze biofotonische en elektrofotonische analyse over dit onderwerp), voor een betere capillaire bloedcirculatie en een betere opname en diffusie van zuurstof naar weefsels en organen.

Zeiss helderveldmicroscoop, 400x vergroting: Rode bloedcellen opgestapeld in rollen
Zeiss helderveldmicroscoop, 400x vergroting: rode bloedcellen opnieuw vrij
Infografie







